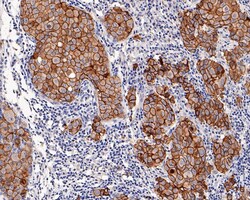
ErbB2/Her2 Antibody (PD00-99), Novus Biologicals 100 &mu;L; Unconjugated:Antibodies,

missing translation for 'onlineSavingsMsg'
Learn More
Learn More
ErbB2/Her2 Antibody (PD00-99), Novus Biologicals™
Rabbit Monoclonal Antibody
Brand: Novus Biologicals NBP3-32423
This item is not returnable.
View return policy
Description
ErbB2/Her2 Monoclonal antibody specifically detects ErbB2/Her2 in Human samples. It is validated for Immunohistochemistry,Western Blot,Immunohistochemistry (Paraffin)
Specifications
| ErbB2/Her2 | |
| Monoclonal | |
| 1 mg/mL | |
| Western Blot 1:1000, Immunohistochemistry, Immunohistochemistry-Paraffin 1:4000 | |
| CD340, CD340 antigen, c-erb B2/neu protein, EC 2.7.10, EGFR2, HER-2, HER2EC 2.7.10.1, herstatin, Metastatic lymph node gene 19 protein, MLN 19, MLN19, NEUHER-2/neu, neuroblastoma/glioblastoma derived oncogene homolog, NGLTKR1, p185erbB2, Proto-oncogene c-ErbB-2, Proto-oncogene Neu, receptor tyrosine-protein kinase erbB-2, Tyrosine kinase-type cell surface receptor HER2, v-erb-b2 avian erythroblastic leukemia viral oncogene homolog 2(neuro/glioblastoma derived oncogene homolog), v-erb-b2 erythroblastic leukemia viral oncogene homolog 2, neuro/glioblastomaderived oncogene homolog (avian) | |
| Recombinant fragment within Human ErbB2/HER2 aa 500-650. (Uniprot: P04626) | |
| 100 μL | |
| Breast Cancer, Cancer, Cellular Markers, Core ESC Like Genes, Oncogenes, Phospho Specific, Protein Kinase, Stem Cell Markers, Tumor Suppressors | |
| 2064 | |
| Store at 4°C short term. Aliquot and store at -20°C long term. Avoid freeze-thaw cycles. | |
| IgG |
| Immunohistochemistry, Western Blot, Immunohistochemistry (Paraffin) | |
| PD00-99 | |
| Unconjugated | |
| PBS (pH7.4), 0.1% BSA and 40% Glycerol | |
| Rabbit | |
| Protein A purified | |
| RUO | |
| Primary | |
| Human | |
| Purified |
Product Content Correction
Your input is important to us. Please complete this form to provide feedback related to the content on this product.
Product Title
Spot an opportunity for improvement?Share a Content Correction